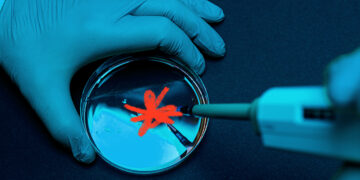
Le virus de l'herpès génétiquement modifié et tueur de cancer pourrait être capable de combattre les tumeurs

Les chercheurs ont examiné le lien entre les niveaux de protéines sanguines et l'incidence longue du COVID. Ils ont découvert que les niveaux de certaines protéines sanguines six semaines après...
Lire plusDetailsAccueil » Dr Stéphane Cohen » Page 294
Dr Stéphane Cohen
Le Dr Cohen écrit depuis 30 ans et est un expert de renommée mondiale dans le domaine de la médecine et du bien-être. Conférencier acclamé, le Dr Stéphane Cohen a donné plus de 100 conférences en Europe ainsi que de nombreuses conférences à l'étranger à divers publics, y compris aux États-Unis.
Une nouvelle étude de suivi de 20 ans a révélé que les personnes qui se sentent seules courent un risque plus élevé de développer un diabète de type 2. De...
Lire plusDetailsRiz blanc ou riz brun : en matière de risque de maladie cardiaque, les céréales sont-elles importantes ?
La maladie coronarienne survient lorsque la plaque s'accumule dans les vaisseaux sanguins qui irriguent le cœur. La maladie coronarienne prématurée est ce qu'on appelle quand elle se développe avant un...
Lire plusDetailsLes personnes âgées devraient-elles vérifier régulièrement leur tension artérielle à la maison ?
L'hypertension, ou hypertension artérielle, est un problème de santé qui touche des millions de personnes. Alors que l'hypertension peut être mortelle lorsque la pression artérielle devient trop élevée, il est...
Lire plusDetailsL'obésité est un facteur de risque pour un certain nombre de causes principales de décès prématurés évitables.Un cinquième des enfants aux États-Unis sont considérés comme obèses.De nouvelles recherches sur des...
Lire plusDetailsUne étude établit un lien entre la pollution de l’air et un risque accru d’accident vasculaire cérébral et de décès associé
Une nouvelle étude a suivi l'effet de la pollution de l'air sur le risque d'avoir un premier AVC et de mourir des suites de problèmes cardiovasculaires.Les chercheurs ont suivi les...
Lire plusDetailsLa pandémie de COVID-19 a-t-elle entraîné des changements dans nos traits de personnalité ?
On considère que les principaux traits de personnalité restent relativement stables pendant la majeure partie de la vie adulte d'une personne, mais peuvent être influencés par des événements personnels stressants.Une...
Lire plusDetailsLes suppléments de calcium pour les adultes de moins de 35 ans améliorent la densité minérale osseuse, selon une étude
Le calcium joue un rôle important dans la santé des os; les carences peuvent entraîner une réduction de la densité osseuse et provoquer des affections telles que l'ostéoporose.La supplémentation en...
Lire plusDetailsLe virus de l’herpès génétiquement modifié et tueur de cancer pourrait être capable de combattre les tumeurs
L'idée d'utiliser des virus pour traiter le cancer est ancienne. Cependant, l'utilisation de virus génétiquement modifiés pour traiter le cancer a commencé à être plus enquêté dans les années 90....
Lire plusDetailsL’ajout de l’haltérophilie à l’exercice cardiovasculaire réduit le risque de mortalité toutes causes confondues
Une nouvelle étude suggère que l'ajout d'haltérophilie à l'exercice aérobique peut réduire davantage le risque de mortalité toutes causes confondues.L'étude révèle que l'haltérophilie est associée à une diminution supplémentaire de...
Lire plusDetailsArticles recommandés
Recette pour fabriquer du gel hydro-alcoolique fait maison
Comment se procurer du matériel médical en ligne ?
Quels sont les avantages de porter des lunettes anti lumiere bleue ?
Les 7 principales causes de décoloration des dents
Les biotechnologies au service de la science
Liposuccion : un traitement de référence pour une silhouette au top
Comment trouver la meilleure mutuelle ?
Quels sont les actes de chirurgie esthétique les plus populaires ?
Qui sommes-nous ?

Ma Clinique : L'information médicale par des professionnels de la santé.
Ma Clinique est géré par des professionnels de la santé qui ont à cœur de fournir des informations médicales précises et actualisées. Nous sommes une équipe de médecins et d'autres professionnels de la santé, et avons des années d'expérience dans le domaine de la médecine.
© 2026 Copyright - Ma Clinique - [email protected]